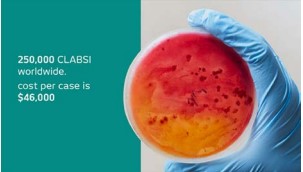
Image 1

Short Communication
Central Line: Associated Blood Stream Infection
Licence:
Attribution-Non-commercial 4.0 International (CC BY-NC 4.0)This license enables reusers to distribute, remix, adapt, and build upon the material in any medium or format for noncommercial purposes only, and only so long as attribution is given to the creator
RFP Journal of Hospital Administration 7(2):p 19-22, July - December 2023. | DOI: NA
How Cite This Article:
Baby SC. Central line: associated blood stream infection. RFP J Hosp Adm. 2023;7(2):55-58.Timeline
Abstract
HAIs are resulting from complications of healthcare. They are linked with high morbidity and mortality. On any given day, 1 in 31 hospital patients has an HAI (an infection while being treated in a medical facility). It is one of the most emerging problems in health care. Additional infections occur in other healthcare settings. Seriously ill patients are particularly vulnerable to serious complications due to HAIs, likely due to factors such as progressively more invasive medical technology and complex medical procedures, increasing immunocompromised status and elderly age, and the rising incidence of antimicrobial resistance. The encouraging news is that many HAIs are preventable when evidence based guidelines are incorporated into patient care. Patients who get a CLABSI have a fever, and might also have red skin and soreness around the central line. If this happens, healthcare providers can do tests to learn if there is an infection present. Healthcare providers must follow a strict protocol when inserting the line to make sure the line remains sterile and a CLABSI does not occur. In addition to inserting the central line properly, healthcare providers must use stringent infection control practices each time they check the line or change the dressing.
References
- 1. www.ncbi.nlm.nih.gov
- 2. https://www.cdc.gov/hai/bsi/bsi.html
- 3. https://www.hopkinsmedicine.org
- 4. https://www.jointcommission.org
- 5. https://www.cdph.ca.gov
Data Sharing Statement
Funding
Author Contributions
Ethics Declaration
Acknowledgements
Conflicts of Interest
About this article
Cite this article
Baby SC. Central line: associated blood stream infection. RFP J Hosp Adm. 2023;7(2):55-58.
Licence:
Attribution-Non-commercial 4.0 International (CC BY-NC 4.0)This license enables reusers to distribute, remix, adapt, and build upon the material in any medium or format for noncommercial purposes only, and only so long as attribution is given to the creator
| Received | Accepted | Published |
|---|---|---|
| April 28, 2023 | May 26, 2023 | December 30, 2023 |
DOI: NA
Keywords
CLABSI - Central Line Associated Blood Stream Infection WHO - World Health Organization CDCP - Centers for Disease Control and Prevention CVC - Central Venous Catheter HAIs - Healthcare-Associated InfectionsCLABSI - Central Line Associated Blood Stream InfectionWHO - World Health OrganizationCDCP - Centers for Disease Control and PreventionCVC - Central Venous CatheterHAIs - Healthcare-Associated InfectionsSearch for Similar Articles
Similar Articles
- Role of Fibrinogen Concentrate and Its Effect on Blood Loss in on Pump Cardiac S...
- From Sequencing to Prediction: Leveraging Next Generation Sequencing & Machine L...
- The Digital Personal Data Protection Act, 2023: Forensic and Medicolegal Implica...
- Perception of “Young Adults” on Integration of Telemedicine in Healthcare Servic...
- Accomplishment of International Patient Safety Goals (IPSG) in Enhancing Patient...
Article Level Metrics
Last UpdatedMonday 26 January 2026, 22:29:24 (IST)
Accesses
Citations
Download citation
Article Keywords
Keyword Highlighting
Highlight selected keywords in the article text.
Timeline
| Received | April 28, 2023 |
| Accepted | May 26, 2023 |
| Published | December 30, 2023 |
licence
This license enables reusers to distribute, remix, adapt, and build upon the material in any medium or format for noncommercial purposes only, and only so long as attribution is given to the creator